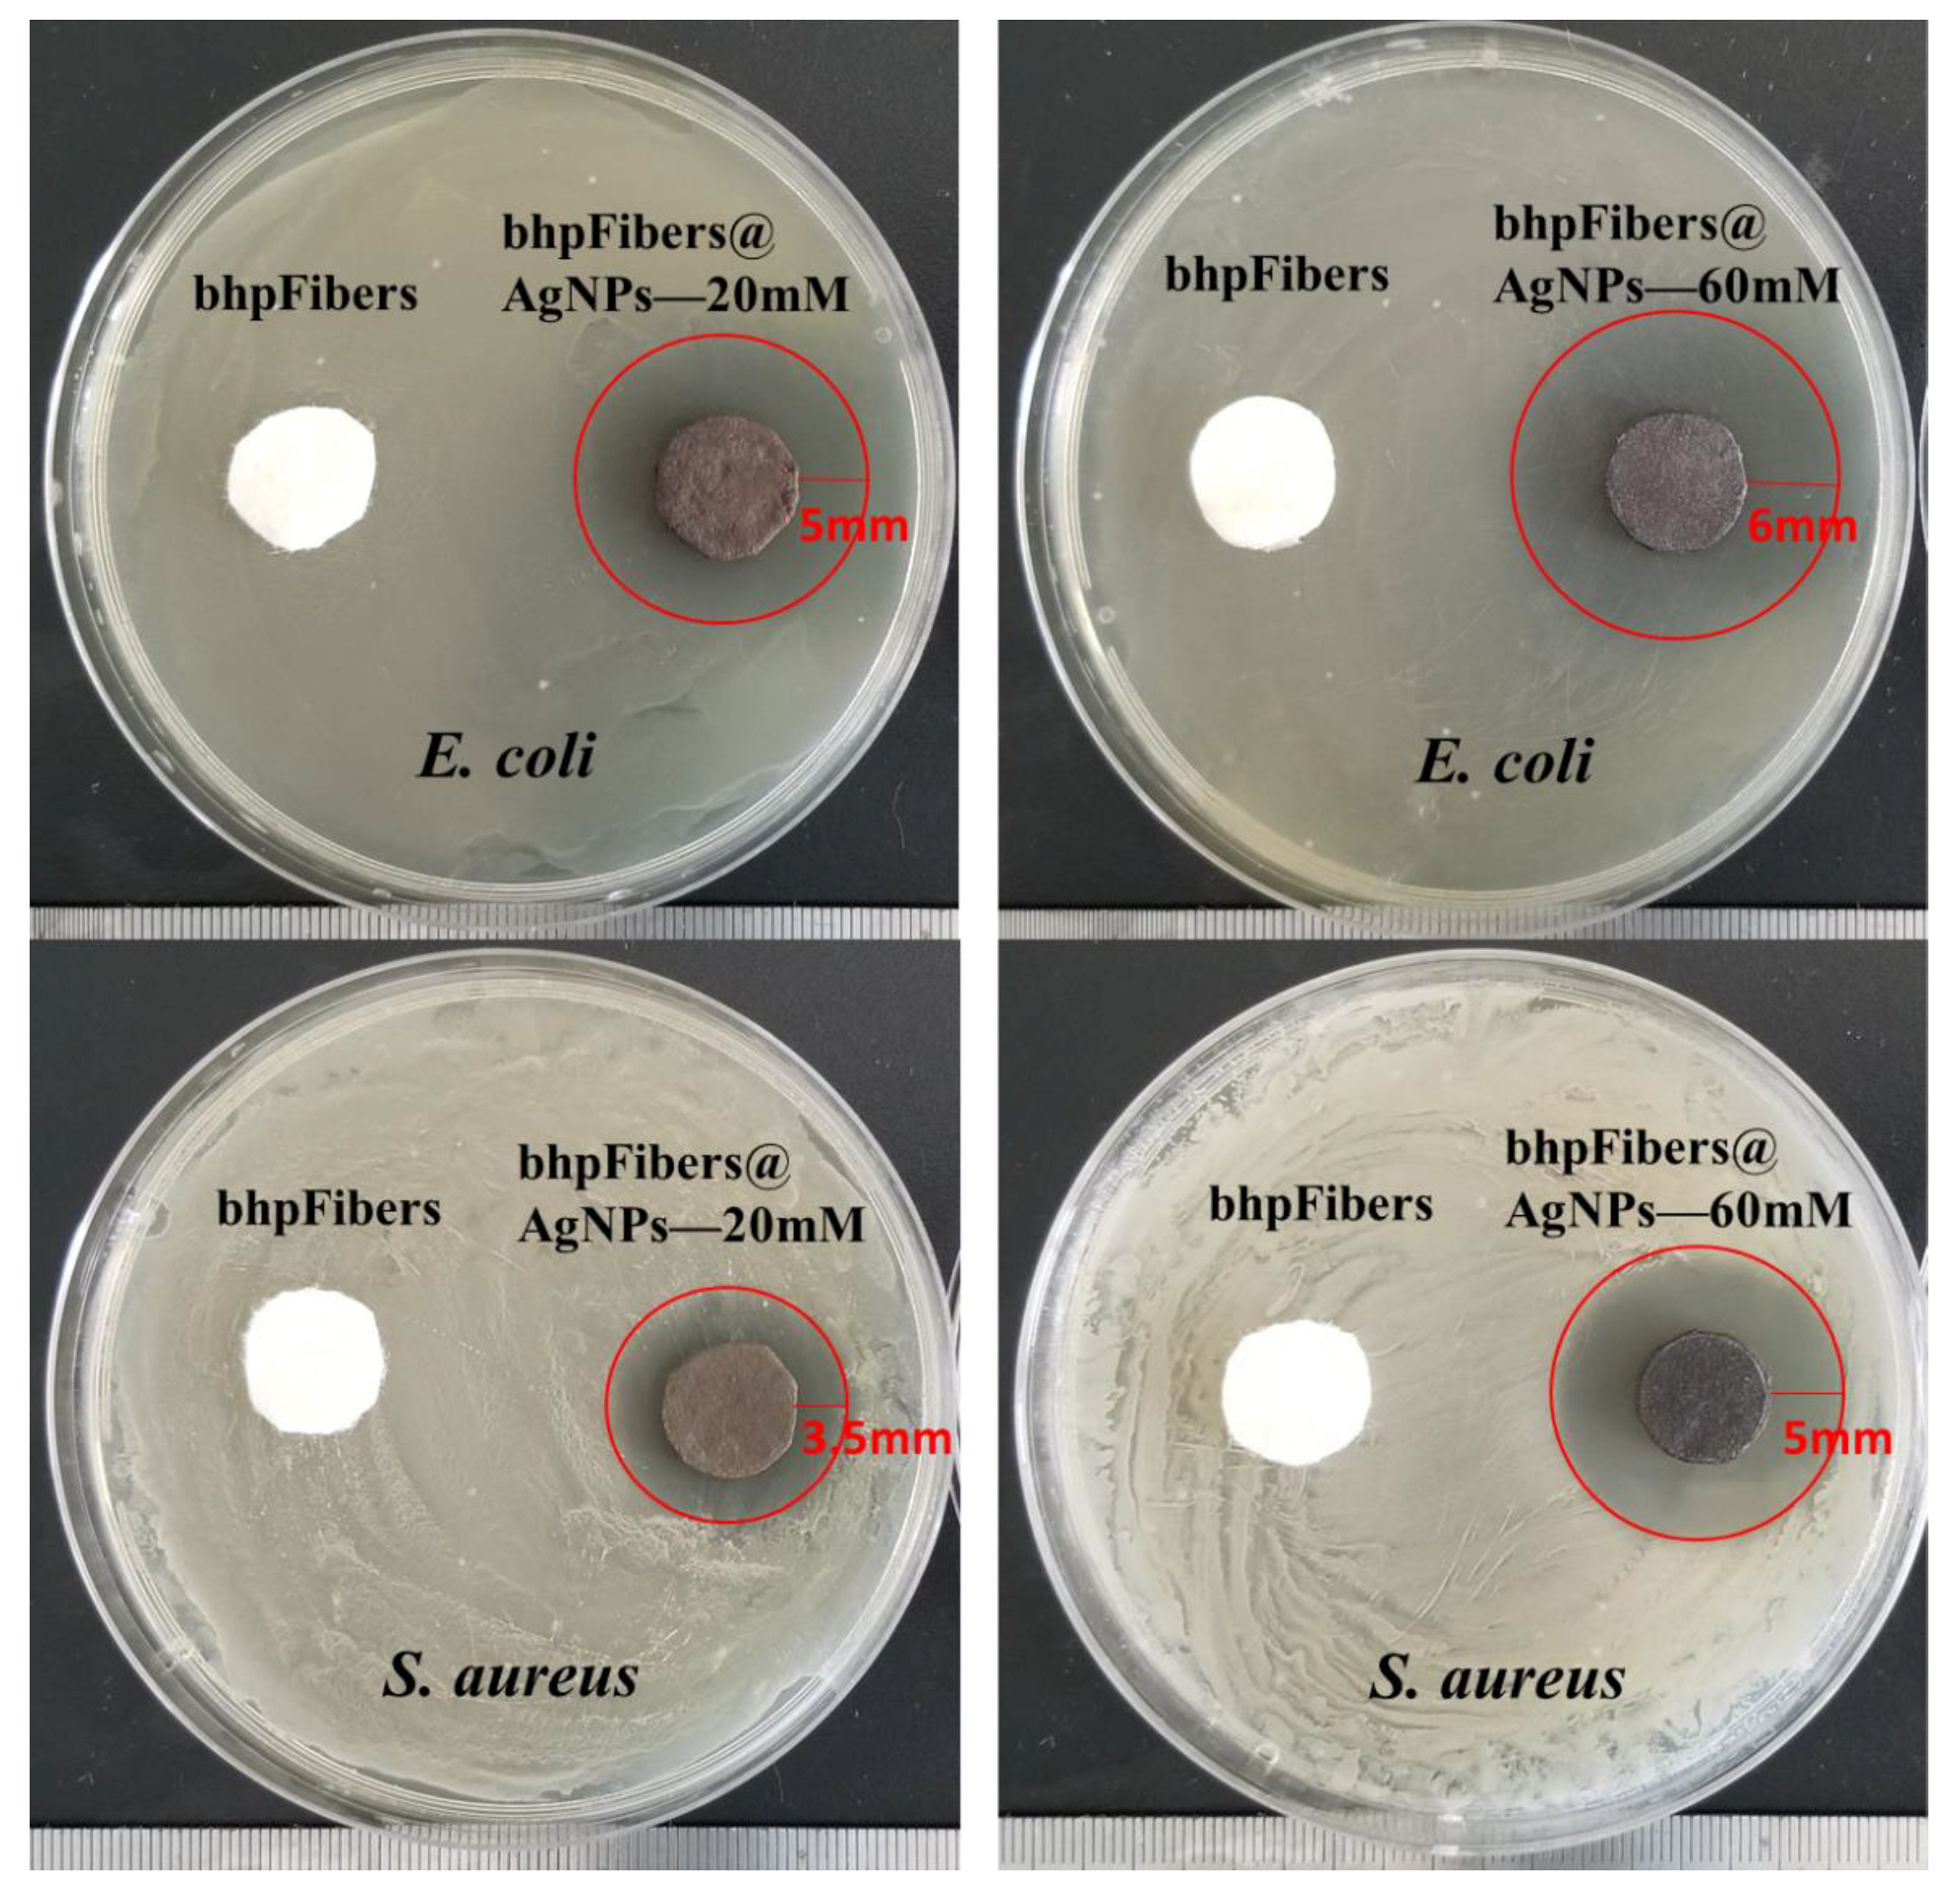
Materials 12 03101 g006

In Situ Synthesis of Silver Nanoparticles on Cellulose Fibers Using D-Glucuronic Acid and Its Antibacterial Application
Abstract
1. Introduction
2. Experimental
2.1. Materials
2.2. Pretreatment of Bleached Hardwood Pulp
2.3. Synthesis of bhpFibers@AgNPs
2.4. Fabrication of bhpFibers@AgNP-based paper
2.5. Characterization
2.6. Antimicrobial Activity Test
3. Results and Discussion
3.1. Effect of DLA on in-situ preparation of AgNPs on bhpFibers
3.2. Characterization of the Pristine bhpFibers and bhpFibers@AgNPs Composites
3.3. The effect of AgNO3 on the deposition amounts of AgNPs on bhpFibers
3.4. Antibacterial Properties of bhpFibers@AgNP-Based Paper
4. Conclusions
Supplementary Materials
Author Contributions
Funding
Conflicts of Interest
References
- Chao, X.; Xin, W.; Zhu, J. Graphene−Metal Particle Nanocomposites. J. Phys. Chem. C 2008, 112, 19841–19845. [Google Scholar]
- Turan, D.; Gunes, G.; Kilic, A. Perspectives of Bio-Nanocomposites for Food Packaging Applications; Springer: Berlin/Heidelberg, Germany, 2018. [Google Scholar]
- Yuan, Y.G.; Gurunathan, S. Combination of graphene oxide–silver nanoparticle nanocomposites and cisplatin enhances apoptosis and autophagy in human cervical cancer cells. Int. J. Nanomed. 2017, 12, 6537–6558. [Google Scholar] [CrossRef]
- Bardajee, G.R.; Hooshyar, Z.; Rezanezhad, H. A novel and green biomaterial based silver nanocomposite hydrogel: Synthesis, characterization and antibacterial effect. J. Inorg. Biochem. 2012, 117, 367–373. [Google Scholar] [CrossRef]
- Xu, Q.; Jin, L.; Wang, Y.; Chen, H.; Qin, M. Synthesis of silver nanoparticles using dialdehyde cellulose nanocrystal as a multi-functional agent and application to antibacterial paper. Cellulose 2019, 26, 1309–1321. [Google Scholar] [CrossRef]
- Wu, W.; Zhang, R.; McClements, D.J.; Chefetz, B.; Polubesova, T.; Xing, B. Transformation and Speciation Analysis of Silver Nanoparticles of Dietary Supplement in Simulated Human Gastrointestinal Tract. Environ. Sci. Technol. 2018, 52, 8792–8800. [Google Scholar] [CrossRef]
- Choi, S.H.; Lee, K.P.; Park, S.B. Preparation and characterization of poly(ester)-silver and nylon-silver nanocomposites. Stud. Surf. Sci. Catal. 2003, 146, 93–96. [Google Scholar]
- Zapataab, P.A.; Páez, M.; Cerda, E.; Azócar, I.; Rabagliati, F.M. Nanocomposites based on polyethylene and nanosilver particles produced by metallocenic “in situ” polymerization: Synthesis, characterization, and antimicrobial behavior. Eur. Polym. J. 2011, 47, 1541–1549. [Google Scholar] [CrossRef]
- Hwang, J.J.; Ma, T.W. Preparation, morphology, and antibacterial properties of polyacrylonitrile/montmorillonite/silver nanocomposites. Mater. Chem. Phys. 2012, 136, 613–623. [Google Scholar] [CrossRef]
- Khude, P.; Majumdar, A.; Butola, B.S. Leveraging the Antibacterial Properties of Knitted Fabrics by Admixture of Polyester-Silver Nanocomposite Fibres. Fibers Polym. 2018, 19, 1403–1410. [Google Scholar] [CrossRef]
- Rehan, M.; El-Naggar, M.E.; Mashaly, H.M.; Wilken, R. Nanocomposites based on chitosan/silver/clay for durable multi-functional properties of cotton fabrics. Carbohydr. Polym. 2018, 182, 29–41. [Google Scholar] [CrossRef]
- Li, Y.; Wang, B.; Sui, X.; Xie, R.; Xu, H.; Zhang, L.; Zhong, Y.; Mao, Z. Durable flame retardant and antibacterial finishing on cotton fabrics with cyclotriphosphazene/polydopamine/silver nanoparticles hybrid coatings. Appl. Surf. Sci. 2018, 435, 1337–1343. [Google Scholar] [CrossRef]
- Shi, D.; Wang, F.; Lan, T.; Zhang, Y.; Shao, Z. Convenient fabrication of carboxymethyl cellulose electrospun nanofibers functionalized with silver nanoparticles. Cellulose 2016, 23, 1899–1909. [Google Scholar] [CrossRef]
- Boateng, J.; Burgosamador, R.; Okeke, O.; Pawar, H. Composite alginate and gelatin based bio-polymeric wafers containing silver sulfadiazine for wound healing. Int. J. Biol. Macromol. 2015, 79, 63–71. [Google Scholar] [CrossRef]
- Chen, H.; Lan, G.; Ran, L.; Xiao, Y.; Yu, K.; Lu, B.; Dai, F.; Wu, D.; Lu, F. A novel wound dressing based on a Konjac glucomannan/silver nanoparticle composite sponge effectively kills bacteria and accelerates wound healing. Carbohydr. Polym. 2018, 183, 70–80. [Google Scholar] [CrossRef]
- Xu, Q.; Xie, L.; Diao, H.; Li, F.; Zhang, Y.; Fu, F.; Liu, X. Antibacterial cotton fabric with enhanced durability prepared using silver nanoparticles and carboxymethyl chitosan. Carbohydr. Polym. 2017, 177, 187–193. [Google Scholar] [CrossRef]
- Moura, M.R.D.; Mattoso, L.H.C.; Zucolotto, V. Development of cellulose-based bactericidal nanocomposites containing silver nanoparticles and their use as active food packaging. J. Food Eng. 2012, 109, 520–524. [Google Scholar] [CrossRef]
- Lu, Y.; Wu, C.; Yang, W.; You, R.; Gang, L.; Chen, Y.; Feng, S. Ag-Coated Cellulose Fibers as Surface-Enhanced Raman Scattering Substrates for Adsorptive Detection of Malachite Green. Materials 2018, 11, 1197. [Google Scholar] [CrossRef]
- Junhui, H.; Toyoki, K.; Nakao, A. Facile In Situ Synthesis of Noble Metal Nanoparticles in Porous Cellulose Fibers. Chem. Mater. 2003, 15, 4401–4406. [Google Scholar]
- Boumbimba, R.M.; Wang, K.; Hablot, E.; Bahlouli, N.; Ahzi, S.; Avérous, L. Renewable biocomposites based on cellulose fibers and dimer fatty acid polyamide: Experiments and modeling of the stress–strain behavior. Polym. Eng. Sci. 2017, 57, 95–104. [Google Scholar] [CrossRef]
- Wang, Q.; Chen, G.; Yu, Z.; Ouyang, X.; Tian, J.; Yu, M. Photoluminescent composites of lanthanide-based nanocrystal-functionalized cellulose fibers for anti-counterfeiting applications. ACS Sustain. Chem. Eng. 2017, 6, 13960–13967. [Google Scholar] [CrossRef]
- Wu, J.; Ning, Z.; Zhang, X.; Jian, X. Cellulose/silver nanoparticles composite microspheres: Eco-friendly synthesis and catalytic application. Cellulose 2012, 19, 1239–1249. [Google Scholar] [CrossRef]
- Guo, X.Y.; Wang, Q.Q.; Lai, Q.Y.; Ouyang, Q.R.; Li, P.; Yu, H.D.; Huang, W. Biomass-Templated Fabrication of Metallic Materials for Photocatalytic and Bactericidal Applications. Materials 2019, 12, 1271. [Google Scholar] [CrossRef]
- Zhu, C.; Xue, J.; He, J. Controlled in-situ synthesis of silver nanoparticles in natural cellulose fibers toward highly efficient antimicrobial materials. J. Nanosci. Nanotechnol. 2009, 9, 3067. [Google Scholar] [CrossRef]
- Maria, L.C.D.S.; Santos, A.L.C.; Oliveira, P.C.; Barud, H.S.; Messaddeq, Y.; Ribeiro, S.J.L. Synthesis and characterization of silver nanoparticles impregnated into bacterial cellulose. Mater. Lett. 2009, 63, 797–799. [Google Scholar] [CrossRef]
- Li, S.M.; Jia, N.; Ma, M.G.; Zhang, Z.; Liu, Q.H.; Sun, R.C. Cellulose–silver nanocomposites: Microwave-assisted synthesis, characterization, their thermal stability, and antimicrobial property. Carbohydr. Polym. 2011, 86, 441–447. [Google Scholar] [CrossRef]
- Yue, X.; Zhang, T.; Yang, D.; Qiu, F.; Li, Z.; Wei, G.; Qiao, Y. Ag nanoparticles coated cellulose membrane with high infrared reflection, breathability and antibacterial property for human thermal insulation. J. Colloid Interface Sci. 2019, 535, 363–370. [Google Scholar] [CrossRef]
- Kamel, S. Rapid synthesis of antimicrobial paper under microwave irradiation. Carbohydr. Polym. 2012, 90, 1538–1542. [Google Scholar] [CrossRef]
- Li, S.M.; Jia, N.; Zhu, J.F.; Ma, M.G.; Xu, F.; Wang, B.; Sun, R.C. Rapid microwave-assisted preparation and characterization of cellulose–silver nanocomposites. Carbohydr. Polym. 2011, 83, 422–429. [Google Scholar] [CrossRef]
- Gong, H.; Liu, M.; Li, H. In situ green preparation of silver nanoparticles/chemical pulp fiber composites with excellent catalytic performance. J. Mater. Sci. 2019, 54, 6895–6907. [Google Scholar] [CrossRef]
- Antony, J.J.; Sivalingam, P.; Siva, D.; Kamalakkannan, S.; Anbarasu, K.; Sukirtha, R.; Krishnan, M.; Achiraman, S. Comparative evaluation of antibacterial activity of silver nanoparticles synthesized using Rhizophora apiculata and glucose. Colloids Surf. B Biointerfaces 2011, 88, 134–140. [Google Scholar] [CrossRef]
- Aladpoosh, R.; Montazer, M.; Samadi, N. In situ green synthesis of silver nanoparticles on cotton fabric using Seidlitzia rosmarinus ashes. Cellulose 2014, 21, 3755–3766. [Google Scholar] [CrossRef]
- Ramkumar, V.S.; Pugazhendhi, A.; Gopalakrishnan, K.; Sivagurunathan, P.; Saratale, G.D.; Dung, T.N.B.; Kannapiran, E. Biofabrication and characterization of silver nanoparticles using aqueous extract of seaweed Enteromorpha compressa and its biomedical properties. Biotechnol. Rep. 2017, 14, 1–7. [Google Scholar] [CrossRef]
- Zhuang, H.; Yang, L.; Zhang, X.X.; Chang, X.W.; Cheng, M.S.; Guo, C. Synthesis of glucuronic acid derivatives via the efficient and selective removal of a C6 methyl group. Tetrahedron Lett. 2016, 58, 423–426. [Google Scholar]
- Tajmir-Riahi, H.A. ChemInform Abstract: Sugar Interaction with Silver Ion. Synthesis, Syectroscopic and Structural Analysis of Silver- Glucuronate Compounds. Cheminform 1986, 17, 43–47. [Google Scholar] [CrossRef]
- Cui, X.; Chang, M.L.; Bao, H.; Zheng, X.; Guo, J. Hyaluronan-Assisted Photoreduction Synthesis of Silver Nanostructures: From Nanoparticle to Nanoplate. J. Phys. Chem. C 2008, 112, 10730–10734. [Google Scholar] [CrossRef]
- Xia, N.; Cai, Y.; Jiang, T.; Yao, J. Green synthesis of silver nanoparticles by chemical reduction with hyaluronan. Carbohydr. Polym. 2011, 86, 956–961. [Google Scholar] [CrossRef]
- Gonzalez, J.C.; Garcia, S.; Bellu, S.; Peregrin, J.M.S.; Atria, A.M.; Sala, L.F.; Signorella, S. Redox and complexation chemistry of the Cr-VI/Cr-V/Cr-IV-D-glucuronic acid system. Dalton Trans. 2010, 39, 2204–2217. [Google Scholar] [CrossRef]
- Abhishek, K.; Meeta, G.; Jain, V.K. A novel reusable nanocomposite for complete removal of dyes, heavy metals and microbial load from water based on nanocellulose and silver nano-embedded pebbles. Environ. Technol. 2015, 36, 706–714. [Google Scholar]
- Wu, J.; Zhang, F.; Zhang, H. Facile synthesis of carboxymethyl curdlan-capped silver nanoparticles and their application in SERS. Carbohydr. Polym. 2012, 90, 261–269. [Google Scholar] [CrossRef]
- Deuber, F.; Mousavi, S.; Federer, L.; Hofer, M.; Adlhart, C. Exploration of Ultralight Nanofiber Aerogels as Particle Filters: Capacity and Efficiency. ACS Appl. Mater. Interfaces 2018, 10, 9069–9076. [Google Scholar] [CrossRef]
- Park, S.Y.; Chung, J.W.; Priestley, R.D.; Kwak, S.-Y. Covalent assembly of metal nanoparticles on cellulose fabric and its antimicrobial activity. Cellulose 2012, 19, 2141–2151. [Google Scholar] [CrossRef]
- Kang, J.-G.; Sohn, Y. Interfacial nature of Ag nanoparticles supported on TiO2 photocatalysts. J. Mater. Sci. 2012, 47, 824–832. [Google Scholar] [CrossRef]
- Cui, J.; Hu, C.; Yang, Y.; Wu, Y.; Yang, L.; Wang, Y.; Liu, Y.; Jiang, Z. Facile fabrication of carbonaceous nanospheres loaded with silver nanoparticles as antibacterial materials. J. Mater. Chem. 2012, 22, 8121–8126. [Google Scholar] [CrossRef]

| Sample | bhpFibers | bhpFibers@AgNPs-20 mM | bhpFibers@AgNPs-40 mM | bhpFibers@AgNPs-60 mM | bhpFibers@AgNPs-80 mM |
|---|---|---|---|---|---|
| AgNPs content | 0 | 8.2 mg/g | 22.4 mg/g | 33 mg/g | 31.8 mg/g |
| Color | ![]() | ![]() | ![]() | ![]() | ![]() |
© 2019 by the authors. Licensee MDPI, Basel, Switzerland. This article is an open access article distributed under the terms and conditions of the Creative Commons Attribution (CC BY) license (http://creativecommons.org/licenses/by/4.0/).
Share and Cite
Chen, G.; Yan, L.; Wan, X.; Zhang, Q.; Wang, Q. In Situ Synthesis of Silver Nanoparticles on Cellulose Fibers Using D-Glucuronic Acid and Its Antibacterial Application. Materials 2019, 12, 3101. https://doi.org/10.3390/ma12193101
Chen G, Yan L, Wan X, Zhang Q, Wang Q. In Situ Synthesis of Silver Nanoparticles on Cellulose Fibers Using D-Glucuronic Acid and Its Antibacterial Application. Materials. 2019; 12(19):3101. https://doi.org/10.3390/ma12193101
Chicago/Turabian StyleChen, Guangxue, Linjuan Yan, Xiaofang Wan, Qiankun Zhang, and Qing Wang. 2019. "In Situ Synthesis of Silver Nanoparticles on Cellulose Fibers Using D-Glucuronic Acid and Its Antibacterial Application" Materials 12, no. 19: 3101. https://doi.org/10.3390/ma12193101
APA StyleChen, G., Yan, L., Wan, X., Zhang, Q., & Wang, Q. (2019). In Situ Synthesis of Silver Nanoparticles on Cellulose Fibers Using D-Glucuronic Acid and Its Antibacterial Application. Materials, 12(19), 3101. https://doi.org/10.3390/ma12193101





